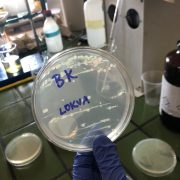

24. listopada 2019. su 4. M i N na dvodnevnom izletu sudjelovali u „Group 4 project“ čiji je cilj povezati znanstvene predmete: Fiziku, Biologiju, Kemiju i Informatiku. Zbog toga je za destinaciju odabran gradić Višnjan u Istri, poznat po zvjezdarnici čiji su uspjesi znani cijelom svijetu. Posjetili smo Znanstveno-edukacijski centar. Maturanti IB programa bili su podijeljeni u pet različitih skupina u kojima su s mentorima sudjelovali u radionicama.
Grupa koja je imala radionicu iz Kemije, razgledala je krajolik i prikupila uzorke koje su analizirali. Upoznali su se s raznim svojstvima tamošnje vode (tvrdoća, pH vrijednost, provodljivost) te sastavom stijena i zemlje (udjelom kalcijeva karbonata i primjesa). Standard Level – grupa iz Biologije dobila je zadatak odrediti gustoću naseljenosti puževa ogrca u okolnom području. Druga grupa iz Biologije – Higher Level je u laboratoriju izvodila eksperimente iz mikrobiologije i enzimatologije. Fizičari i informatičari učili su o astrofotografiji. Dok su fizičari učili o šumu u fotografiji i kako fotografirali noćno nebo, informatička je grupa radila na posvjetljivanju i čišćenju fotografije, kako bi uspješno razvili poznate slike svemira.
Prvi dan predavanja bio je zaključen obilaskom zvjezdarnice i zanimljivim predavanjem voditelja zvjezdarnice, Korada Korlevića. Drugi je dan završio radionicama i prezentacijama u kojima je svaka grupa predstavila svoj rad.
Ovim su projektom učenici unaprijedili svoje vještine: rada u timu, kritičkog razmišljanja i samoevaluacije. Također su dobili nesvakidašnju priliku raditi sa stručnjacima te vidjeti kako rade znanstvenici.